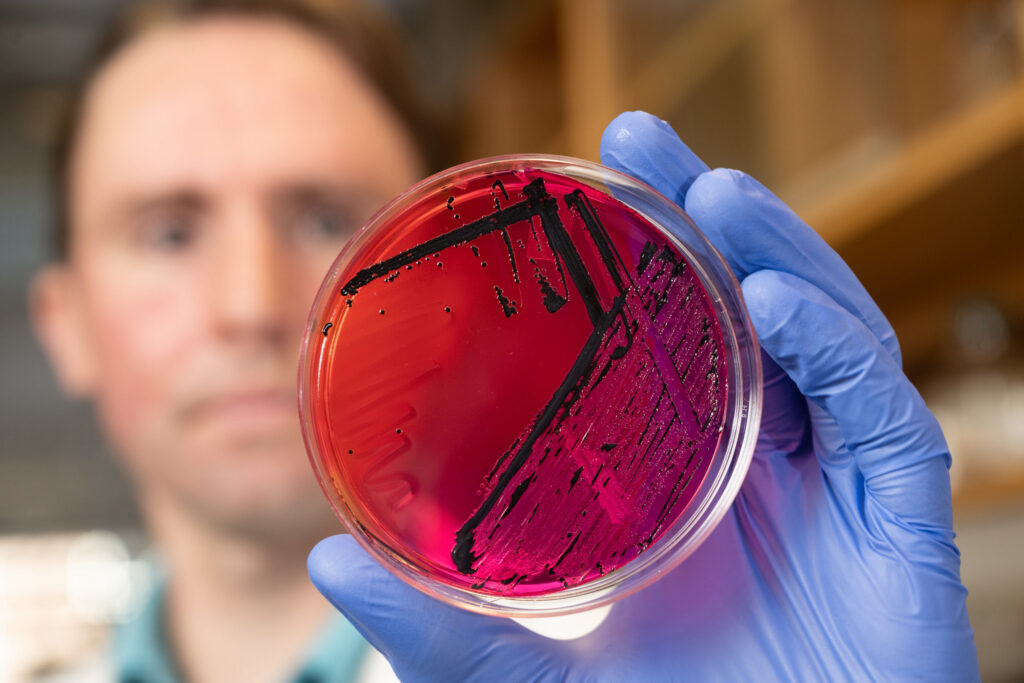
Man looking at bacteriology sample in veterinary diagnostic lab

Diagnostic Services
Avian diagnostics
We offer disease testing services and flock health support for the U.S. poultry industry including:
- Commercial poultry
- Backyard flocks
- Waterfowl flocks
- Upland gamebirds
- Pet birds
We provide a wide array of avian disease diagnostic services, including avian influenza virus and Newcastle disease virus testing, virus isolation in embryonated eggs and Salmonella Enteritidis culture and real-time PCR.

Bacteriology
Microbiologists isolate and identify bacterial and fungal pathogens. Specimens accepted may be sourced from live animals or cadavers.
- Microbiological culture and identification of pathogenic bacteria and fungi are performed.
- Antimicrobial susceptibility tests are performed to detect antibiotic-resistant bacteria to aid management when appropriate.
- Immunodiagnostic testing is available for systemic fungal pathogens.
Specialties
- Antimicrobial susceptibility testing of non-fastidious bacteria
- Antimicrobial susceptibility testing of non-tuberculous Mycobacterium spp.
- Blood culture (automated monitoring with rapid turnaround if Bactec™ bottles submitted)
- Anaerobic bacteriology, including Clostridial diseases
- Dermatophytes and other fungal pathogens
- Gastrointestinal and reproductive Campylobacter culture
- Environmental surveillance for Salmonella
- Leptospira microagglutination serology
Chemistry and toxicology
The chemistry and toxicology section offers veterinarians, researchers, and animal owners a variety of chemical analyses which aid in the determination of an animal’s nutritional status, the measurement of therapeutic drug concentrations, and the diagnosis of environmentally-linked toxicoses.
Trace- and macro-mineral analyses are available from biological tissues (e.g., blood, serum, bone, kidney, and liver) as well as feeds, mineral supplements, water, and forages to assess levels of nutritionally important substances such as copper, selenium and Vitamin E.
We routinely handle liver biopsies for elemental analysis.
Chemical tests available for potential toxicoses include:
- Strychnine
- Arsenic
- Nitrate
- Mercury
- Lead
- Acetylcholinesterase
Other available tests include serum bromide analysis and qualitative analysis of bladder calculi.


Clinical hematopathology
We provide diagnostic testing for hematopoietic cancers in companion animals, primarily dogs and cats. Through testing and research, we aid veterinarians in the accurate diagnosis of these diseases.
Diagnostic tests
- Flow cytometry
- Polymerase chain reaction for antigen receptor rearrangement (PARR)
- Ki67
- Cell block
Clinical pathology
Clinical pathology supports the diagnosis of disease using laboratory testing of blood and other bodily fluids and tissues, and microscopic evaluation of individual cells.
We offer testing on all animal species in the areas of hematology, biochemistry, cytology, immunocytochemical staining, cytochemical staining, immunofixation, and urinalysis.
Most common tests run:
- Hematology
- Coagulation testing
- Biochemistry
- Urinalysis
- Blood gas analysis
- Cytology
- Immunocytochemical staining
- Cytochemical staining
- Protein electrophoresis/immunofixation


Histology
We provide histology services for tissue samples submitted through our biopsy and necropsy services. We also provide immunohistochemistry services for the identification of antigens in tissues. The antigen of interest may be a natural component of the host tissue (e.g. cell surface receptors or cell constituents) or foreign to the host (e.g. a protein associated with an infectious agent).
Molecular diagnostics
Our advanced techniques allow for both rapid and highly sensitive detection of nucleic acids to aid in the diagnosis of infectious diseases. We can test a wide variety of sample types, including blood, swabs, and tissues. We provide both polymerase chain reaction (PCR) and sequencing services.


Parasitology
We provide full-service, diagnostic support for the detection of parasitic infections in domestic and wild animals. Accurate detection of parasites benefits animals by helping to improve animal health. The section also serves to safeguard public health through the rapid and reliable detection of zoonotic parasites.
Services provided by the parasitology section include detection and identification of domestic and wild animal parasites from animal feces, tissues, fluids, or environmental samples.
Diagnostic tests
- Quantitative centrifugation flotation techniques
- Direct fecal smears (wet mounts)
- Baermann technique for recovery of nematode larvae
- Sedimentation technique for recovery of trematode eggs
- Heartworm antigen/antibody testing and Knott’s technique for microfilariae in blood
- Tritrichomonas foetus – culture and PCR
Specialized services
- Parasite identification – includes those from wildlife
- Nematode larval cultures
- Direct immunofluorescent antibody tests for Giardia and Cryptosporidium
- Fecal egg count reduction tests for the detection of anthelmintic resistance
- Anthelmintic evaluation
- PCR detection and identification of endoparasites – includes genotyping of Giardia and Cryptosporidium as well as specific identification of ruminant livestock strongyles
Pathology
Pathology includes both necropsy and biopsy. Our goal is to diagnose animal disease and discover the processes and agents causing disease.
Specialties
- Surgical pathology/oncologic pathology
- Dermatopathology
- Food animal diseases
- Wildlife and exotic pathology
- Bone and joint pathology
- Endometrial pathology
- Respiratory pathology
- Ophthalmologic pathology
- Neuropathology


Specialized infectious disease
We handle hundreds of tests each day, yet we strive to give each case our personal attention.
Tests
- Toxoplasma gondii IgM and IgG (ELISA, canine and feline only)
- Bartonella IgG serology (ELISA, feline only)
- Rocky Mountain spotted fever (IFA, canine only)
- Ehrlichia canis IgG (IFA, canine only)
- Anti-platelet flow cytometry (canine only)
- Fever unknown origin PCR panel (feline)
- Blood donor PCR panel (canine and feline only)
- Neurological PCR panels (canine and feline only)
- Infectious disease PCRs
Transmissible spongiform encephalopathies
We specialize in diagnostics for transmissible spongiform encephalopathies, including:
- Chronic wasting disease, including:
- Enzyme-linked immunosorbent assay (ELISA)
- Immunohistochemistry
- Testing performed in conjunction with the Colorado Division of Wildlife, Colorado Department of Agriculture, and the USDA
- Bovine spongiform encephalopathy, including ELISA (USDA program only)
- Scrapie, including immunohistochemistry


Virology
We are uniquely positioned to perform diagnostic testing using timeless classical methods while harnessing the application of novel technologies. We are dedicated to offering diagnostic testing for the major viral pathogens affecting a variety of species while adapting traditional methods to contemporary techniques. This allows us to further characterize viral pathogens and deliver faster results. Our diagnostic approach is intended to demonstrate how innovative workflows have the potential to inform cost-effective management and mitigation strategies that can limit disease transmission.
Specialties
- Rabies antigen testing
- West Nile virus testing
- Equine infectious anemia testing
- Canine distemper virus and parvovirus vaccine titers
- Bluetongue and epizootic hemorrhagic disease virus and serotype testing
- Ruminant, equine, and canine diarrhea testing
- Ruminant and equine respiratory virus serology
- Feline herpesvirus, calicivirus, and panleukopenia virus vaccine titers